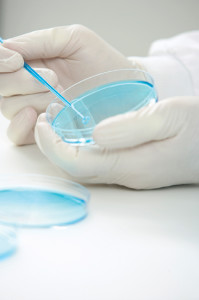
UnsuccessfulWrongfulBirthClaim199x300jpg

Unsuccessful Wrongful Birth Claim
11 Sep 2013
Case history
Keeden Waller was conceived by IVF, which was performed by Dr James. Keeden inherited antithrombin deficiency (ATD) from his father. Soon after his birth, Keeden suffered an extensive cerebral sinovenous thrombosis (CSVT). Keeden is now profoundly disabled.
The Wallers alleged that Dr James breached his duty of care by failing to inform or cause them to be informed of the hereditary aspects of ATD. They asserted if they had been informed, they would not have had Keeden.
Medico-legal issues
Two separate claims were filed by the Wallers. The first claim, which was a “wrongful life” claim1 was dismissed by the High Court in 2006. As Kerrie Chambers noted in her previous article, the logical impossibility of comparing nonexistence (which cannot be experienced) to a damaged existence, led the High Court to the finding that no meaningful assessment of damages could be made.
The second claim brought by Keeden’s parents was a claim for the cost of raising Keeden, alleging that he would not have been born but for Dr James’ negligence.
During the Wallers’ first consultation with Dr James, he gave them the contact details of a genetic counsellor. It was the Wallers’ evidence that they did not have a clear understanding as to why this was given to them. They stated they tried to call the number once; however, they did not try again. No further discussions were had regarding ATD and Keeden was conceived by IVF.
While Justice Hislop held that Dr James did breach his duty of care by not making the purpose of the referral clear, their claim failed, as they were not able to provide any evidence that the CSVT was caused by the ATD deficiency. Justice Hislop was therefore of the opinion that the loss suffered was not a reasonably foreseeable consequence of Dr James’ breach of duty.
The Wallers also tried to argue that Keeden would not have been born “but for” Dr James’ breaches, and as a consequence, he would not have suffered the stroke and the subsequent losses. However, the Court found that the ATD had not caused Keeden any loss, as the stroke was not caused by the ATD.
While it was unnecessary for Justice Hislop to determine damages, he made some comments regarding damages in the event the matter was appealed. He stated that any damages would be limited to when Keeden turned 18, when his parents’ legal obligations would cease. The other interesting point Justice Hislop made was that as the Wallers wanted a child, damages would have been awarded only for the losses occasioned by the CSVT, not the ordinary costs of raising a child. It is however important to note that this claim was prior to the introduction of the NSW Civil Liability Act 2002 which now limits any damages for wrongful birth claims in NSW to the additional costs of raising a disabled child.2
Summary points
- Doctors should discuss with patients the purpose of any referrals and the consequences of failing to attend.
- Practices should have a follow up system to track any patients who may be at risk if they fail to attend.
By Sharon Russell, Claims Manager, MDA National.
1 Waller v James [2006] HCA; (2006) 226 CLR 136
2 S71 Civil Liability Act 2002 (NSW)
Reportable Deaths and Coronial Matters
MDA National's Daniel Spencer (Case Manager - Solicitor) and Karen Lam (Medico-Legal Adviser) discuss when a person's death should be reported to the Coroner and what to do if the Coroner requests a statement or report.
15 May 2025
Death Certificates
When a doctor can write a death certificate (where the death does not need to be reported to the Coroner), considerations when writing the death certificate and how to complete it accurately.
15 May 2025
Communication in healthcare teams
Why good and effective communication is a vital part of delivering quality and safe patient care
15 May 2025

Doctors, Let's Talk: Setting Boundaries At Work
A conversation with Nicola Campbell, Psychiatry Registrar, that explores the necessity of setting professional boundaries as a Junior Doctor.
07 Dec 2022